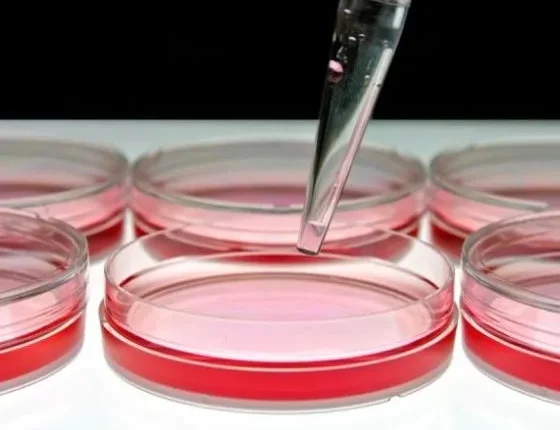

Τι είναι το τρυβλίο Petri
Το τρυβλίο Petri ή δίσκος Πέτρι, είναι ένα γυάλινο ή πλαστικό ρηχό στρογγυλό πιάτο, που αποτελεί ζωτικής σημασίας εργαλείο στα επιστημονικά εργαστήρια, αφού μέσα σ’ αυτό καλλιεργούνται μικροοργανισμοί.
Οι χρήσεις του συγκεκριμένου εξοπλισμού ποικίλλουν, ωστόσο είναι πιο γνωστό για την συγκράτηση ενός μέσου καλλιέργειας, κατά την οποία τα κύτταρα, τα βακτήρια και οι ιοί μπορούν να αναπτυχθούν, να καλλιεργηθούν και να μελετηθούν. Οι περισσότερες μεγάλες επιστημονικές ανακαλύψεις έχουν βοηθηθεί σε μεγάλο βαθμό από τη χρήση τρυβλίων Petri, είτε πρόκειται για την απλή δομή ενός ιού, είτε για τη δυνατότητα κλωνοποίησης.
Η συγκεκριμένη εφεύρεση πήρε το όνομά της από τον Γερμανό βακτηριολόγο Julius Richard Petri, που συνέλαβε την ιδέα το 1877, απογοητευμένος με τα υφιστάμενα εργαλεία για καλλιέργεια μικροοργανισμών. Οι περισσότεροι επιστήμονες μέχρι τότε χρησιμοποιούσαν ρηχά κύπελλα ή φιάλες, που ήταν δύσκολες στη χρήση και υπήρχε πάντα μεγάλος φόβος μόλυνσης. Ο Petri σκέφτηκε ότι ένα ρηχό κυκλικό πιάτο θα είναι ευκολότερο στη χρήση και επίσης θα είναι εύκολο να έχει καπάκι. Το καπάκι κρατάει το τρυβλίο Petri μακριά από την ρύπανση, ενώ το σχήμα του κάνει πιο εύκολο να οργανωθούν μέσα σ’ αυτό ποικίλες συνθέσεις μικροοργανισμών.

Οταν ένα τρυβλίο Petri χρησιμοποιείται για την καλλιέργεια κυττάρων, είναι συνήθως γεμάτο με ένα μέσο ανάπτυξης που κατασκευάζεται από άγαρ, ένα ζελέ που γίνεται από εκχυλίσματα κόκκινων φυκιών και μια ποικιλία θρεπτικών συστατικών. Το μέσο ανάπτυξης έχει μια ζελατινώδη υφή, όπου ευδοκιμούν οι περισσότερες καλλιέργειες, αν και μερικές φορές τα θρεπτικά συστατικά θα πρέπει να μεταβληθούν, προκειμένου να καλύψουν τις ανάγκες του οργανισμού που καλλιεργείται. Για να ικανοποιήσει αυτές τις ανάγκες ένας επιστήμονας-ερευνητής μπορεί να χρειαστεί αρκετές εβδομάδες και να προσαρμόσει στο κατάλληλο περιβάλλον μια σειρά από τρυβλία Petri. Μόλις η καλλιέργεια αρχίσει να αναπτύσσεται ο μικροοργανισμός μπορεί να γίνει αντικείμενο έρευνας.
Υπάρχουν κι άλλες χρήσεις για τα τρυβλία Petri: Πολλά σχολεία, για παράδειγμα, τούς χρησιμοποιούν για να διδάξουν πράγματα σχετικά με τη βλάστηση των σπόρων, καθώς η διαφάνεια του τρυβλίου επιτρέπει στον παρατηρητή να παρακολουθήσει κάθε βήμα της ανάπτυξης. Επιπλέον αυτό το πιάτο χρησιμοποιείται για την ανατομή, καθώς είναι ιδανικό για να τοποθετηθεί κάτω από ένα μικροσκόπιο. Μπορεί, επίσης, να χρησιμοποιηθεί ως βάση για πειραματικούς σκοπούς, όπως η μεταφορά υγρών σε αποστειρωμένα δοχεία ή για την αφαίρεση υγρασίας (ξήρανση) υγρών που είναι προς μελέτη.
Οι χρήσεις του τρυβλίου Petri συνεχώς διευρύνονται από την επιστημονική κοινότητα, γι’ αυτό και είναι ένα εργαστηριακό εργαλείο που θεωρείται μάλλον απίθανο να εγκαταλειφθεί στο εγγύς μέλλον.
Οι σημαντικές εξελίξεις στον τομέα της επιστήμης, όπως η ανάπτυξη των κυττάρων σε ολοκληρωμένα ηλεκτρονικά κυκλώματα, η κλωνοποίηση οργάνων και η κατανόηση των ιών, έχουν επιτευχθεί με τη βοήθεια των «ταπεινών» τρυβλίων Petri.
Αν και άλλες μέθοδοι μελέτης οργανισμών στο εργαστήριο, συνεχίζουν να αναπτύσσονται, η ανάγκη για τη βασική ικανότητα ταχείας καλλιέργειας οργανισμών σε ένα αποστειρωμένο περιβάλλον, δεν πρόκειται ποτέ να εξασθενίσει.
